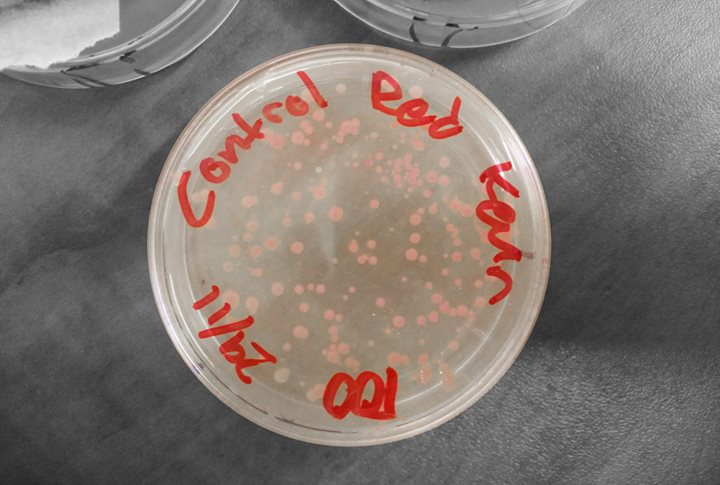
Atelier / Ton premier OGM!

TON PREMIER OGM: ATELIER DE TRANSFORMATION DE PLASMIDE
BY / PAR: Kevin Chen, Bricobio
BILINGUE / BILINGUAL
PRICE / PRIX: Members & Students - $40 / Regular - $50
REGISTRATION / RÉSERVATION: https://easternbloc.ca/fr/laboratoire/ateliers/ton-premier-ogm-atelier-de-transformation-de-plasmide/inscription/0 DATES: 18 mars 2017
TIME / HEURE: 12 h à 15 h
English below
DESCRIPTION / Dans cet atelier les participants créeront leur premier organisme génétiquement modifié. Ils feront une transformation de plasmide, laquelle implique l’introduction d’une pièce étrangère d’ADN à une cellule bactérienne. Le résultat est une bactérie qui aura une nouvelle couleur (rouge, vert, bleu etc.) comparé à sa couleur d’origine, soit blanc ou beige clair. Les participants apprendront les bases de la génétique -- l’ADN, l’ARN, la protéine et d’autres mécanismes cellulaires -- ainsi que les bases des organismes génétiquement conçus et la résistance antibiotique.
*******************************************************************************
YOUR FIRST GMO: PLASMID TRANSFORMATION WORKSHOP
DESCRIPTION / In this workshop, participants will create their first genetically modified organism. They will be doing a plasmid transformation, which involves introducing a foreign piece of DNA to a bacterial cell. The result is a bacteria that will have a new colour (red, green, blue etc.) compared its normal colour of white or light beige. Participants will learn the fundamentals of DNA, RNA, protein, and other cellular mechanisms, as well as the basics of genetically engineered organisms and antibiotic resistance.
Popularité
Distance
Prix
Atelier / Ton premier OGM!
1
Toutes les sorties
30
Concerts
38
Art & Musées
17
Festivals & Marchés
104
Party & Nightlife
7
Théâtre & Humour
90
Jeux & Attractions
166
Bars & Cocktails
1720
Restaurants étonnants
15
LGBT
944
Sports & Fitness
111
Danse
1015
Poutines
41
Coups de cœur de So Montréal
Atelier / Ton premier OGM!
variable
18 mars 2017 à 12h00 au 18 mars 2017 à 15h00
Description
PLUS D'INFOS